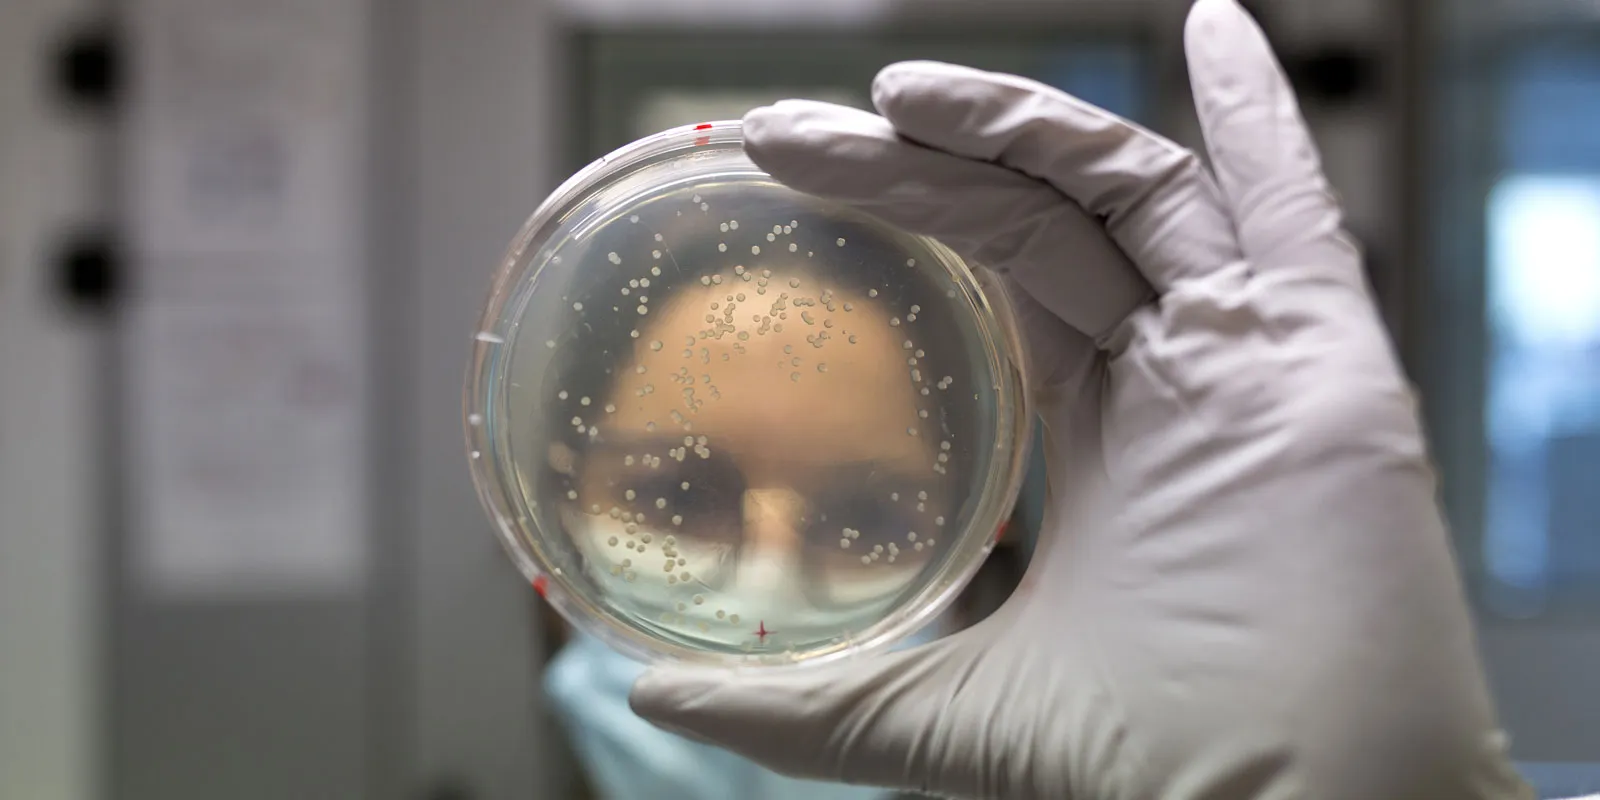
Une chercheuse de Généthon tient un flacon devant elle

👩⚕️Grâce à vous, une révolution de la médecine
Grâce à vous, une révolution de la médecine change la vie des malades
Grâce à la mobilisation exceptionnelle des Français pour le Téléthon, grâce à vous, le monde des malades rares a changé. Il connait une véritable révolution. Des enfants atteints de maladies autrefois incurables et mortelles sont sauvés, bénéficiant des travaux de recherche innovants réalisés dans les laboratoires de l’AFM-Téléthon.
La thérapie génique, en particulier, portée par notre Association parfois contre vents et marées, montre aujourd’hui son efficacité pour le traitement de maladies rares. Déjà, des milliers d’enfants ont pu en bénéficier. C’est le cas d’Ibrahima, ambassadeur du Téléthon 2023 : atteint d’une amyotrophie spinale - une maladie qui prive petit à petit les enfants de tous mouvements et engage leur pronostic vital dans sa forme la plus sévère - le petit garçon a pu bénéficier du traitement de thérapie génique issu des recherches menées à Généthon. « Une chance incroyable » confient ses parents car aujourd’hui, à 2 ans et demi, Ibrahima court, saute, danse… comme tous les enfants de son âge.
Découvrez l'histoire d'Ibrahima, ambassadeur du Téléthon 2023.
Frédéric Revah, Directeur de Généthon, témoignait sur le plateau du Téléthon 2022: « Si on m’avait dit qu’on soignerait des enfants atteints d’amyotrophie spinale, je n’y aurais pas cru »
La thérapie génique a également offert un autre destin à Jules, 7 ans, qui est atteint d’une autre pathologie rare et très sévère : la myopathie myotubulaire. Pour Anaïs, sa maman, cette maladie le rendait « prisonnier de son corps » : incapable de respirer seul, de bouger, de parler…. Grâce aux recherches menées par Ana Buj Bello, chercheuse à Généthon, Jules a bénéficié d’un traitement de thérapie génique. Depuis, il a fait d’incroyables progrès puisqu’il marche, court, monte les escaliers, fait du vélo, et est devenu un véritable moulin à paroles pour le plus grand bonheur de ses parents !
Ces victoires de la recherche, cette révolution médicale, c’est grâce à vous, grâce à la mobilisation du Téléthon. D’autres enfants atteints de maladies rares sont en attente d’un traitement. Pour eux, le Téléthon peut tout changer ! Vos dons sont le moteur de nos victoires.
* La part de financement du laboratoire Généthon issue du Téléthon provient des recettes des animations
💊Grâce à vous, les traitements de demain
Grâce à vous, les traitements de demain sont à l’essai
Les essais se multiplient et s’accélèrent. Etape indispensable préalable à la mise sur le marché de nouveaux médicaments, les essais cliniques soutenus par l’AFM-Téléthon se multiplient : 38 essais chez l’homme sont en cours dans 29 maladies différentes, des maladies du muscle mais aussi de la peau, du sang, du cerveau, de la vision…
Parmi eux, un traitement pourrait changer le quotidien des malades atteints du syndrome de Crigler-Najjar, une maladie rare du foie qui les oblige à passer entre 10 et 12h par jour sous des lampes UV bleues, afin de maintenir leur taux de bilirubine à un niveau inférieur au taux de toxicité. Sans cette contrainte qui rythme leur vie, les malades risquent d’importantes atteintes du cerveau, voire le décès. L’essai mené par le laboratoire Généthon vient de dévoiler ses premiers résultats : des malades traités avec la plus forte dose de thérapie génique se passent de photothérapie depuis près de deux ans ! Une nouvelle démonstration d’efficacité de la thérapie génique pour un traitement développé par le laboratoire de l’AFM-Téléthon.
Kelly, 15 ans, ambassadrice du Téléthon 2023, est atteinte du syndrome de Crigler-Najjar. Découvrez son histoire.
Une autre maladie, emblématique du Téléthon, fait l’objet d’un essai clinique avec un médicament de thérapie génique issu des recherches de Généthon : la myopathie de Duchenne. C’est un immense espoir pour les enfants atteint de cette maladie génétique rare évolutive qui touche l’ensemble des muscles de l’organisme et qui concerne 1 garçon sur 3500 !
Benjamin, ambassadeur du Téléthon 2022, est atteint de myopathie de Duchenne. Découvrez son histoire :
Une myopathie des ceintures (liée au gène FKRP) fait également l’objet d’un essai de thérapie génique, après 30 ans de recherches menées à Généthon par Isabelle Richard et son équipe. Cette maladie se manifeste par une dégénérescence musculaire pouvant entraîner la perte de la marche et des complications cardiaques et/ou respiratoires. L’essai démarré en 2023 concerne les malades âgés de 16 ans et plus, toujours en capacité de marcher. Son objectif est de stopper l’évolution de la maladie, peut-être même de la faire reculer !
Pierre est atteint de cette maladie. Sur le plateau du Téléthon 2021, il expliquait son quotidien :
D’autres essais cliniques pour des traitements issus des recherches menées par les chercheurs du Téléthon sont en cours, qu’il s’agisse de thérapie génique ou de thérapie cellulaire.
🧪Grâce à vous, la recherche
Grâce à vous, la recherche continue de progresser
Guérir des maladies rares longtemps considérées comme incurables, c’est l’objectif prioritaire de l’AFM-Téléthon. Si les premières grandes victoires thérapeutiques sont là, 95% des maladies rares restent encore sans traitement. Pour les malades concernés, il y a urgence !
Léon, un petit garçon de 9 ans, ambassadeur du Téléthon 2023, est atteint d’une neuropathie à axones géants, une maladie génétique dégénérative, pour laquelle il n’existe pas de traitement. Pour lui, le Téléthon peut tout changer !
Découvrez l'histoire de Léon : "Si je deviens plus fort que ma maladie, ce sera grâce à vous"
Grâce au soutien du Téléthon, les recherches continuent pour de nombreuses maladies, permettant une meilleure compréhension de leurs mécanismes et la mise au point de thérapies innovantes.
Au total, plus de 200 chercheurs et programmes de recherche sont financés chaque année par l’AFM-Téléthon, et plus de 600 experts scientifiques travaillent au sein des laboratoires : Généthon, devenu en quelques années leader de la thérapie génique pour les maladies rares, I-Stem, pionnier de la recherche sur les cellules souches et la thérapie cellulaire, et l’Institut de Myologie, expert du muscle et ses maladies.
De même, la Fondation maladies rares, majoritairement financée par l’AFM-Téléthon, soutient des équipes de recherche et crée des passerelles entre recherche académique et industrie pour le développement de médicaments.
Votre don au Téléthon finance la recherche. Nos chercheurs et nos laboratoires la transforment en traitements. Pour le Téléthon 2023, ensemble, nous pouvons construire les victoires de demain !
* La part de financement du laboratoire Généthon issue du Téléthon provient des recettes des animations
🤝Grâce à vous, l'accompagnement au quotidien
Grâce à vous, les malades bénéficient d’un accompagnement au quotidien
Engagée dans la recherche scientifique, l’AFM-Téléthon l’est aussi dans l’accompagnement des malades et de leur famille. Grâce à vous, l’Association accompagne les malades au quotidien, pour réduire les situations de handicap générées par la maladie, et aider les malades et les familles à réaliser leur projet de vie, en attendant les traitements.
Accès au diagnostic, à des soins adaptés, accompagnement de proximité, recherche de solutions innovantes… l’Association mène une lutte sur tous les fronts et est présente partout en France, grâce à ses réseaux de proximité. En 2023, près de 7800 malades et leur famille ont été accompagnés par 181 professionnels répartis dans 16 services régionaux sur tout le territoire.
Ivy, ambassadrice du Téléthon 2023, est atteinte d'une myopathie non identifiée et est accompagnée par les services de proximité de l'AFM-Téléthon. Découvrez son histoire.
L’AFM-Téléthon est également le fondateur et le principal financeur de la Plateforme maladies rares qui rassemble les principaux acteurs français et européens des maladies rares.
Découvrez les actions de l’AFM-Téléthon pour accompagner les malades